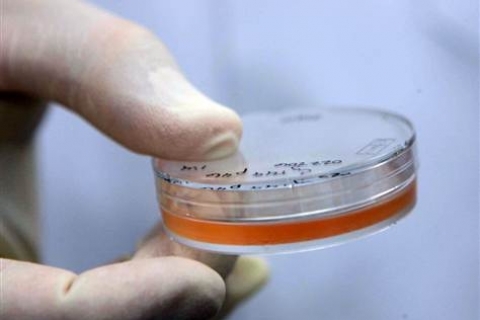
Иммунная система зависит от стволовых клеток

Новости - Страница 37
2012-05-03 23:23:00

Необратимые повреждения зубной эмали обнаружены при регулярном употреблении энергетических и спортивных напитков
2012-05-03 23:21:00

Инновационные наночастицы для МРТ-диагностики разработаны исследователями из Госпиталя МакЛина при Медицинском факультете Гарварда
2012-05-03 23:16:00

Британские ученые на основании изучения клеток крови выявляют рак молочной железы за 3 года до выявления стандартными методами
2012-05-03 15:45:00

Паразитирующий в речной рыбе печеночный сосальщик вызывает развитие рака печени. Ученые из Института цитологии и генетики Российской академии наук
2012-05-03 15:32:00

Установлен механизм действия стволовых клеток на функции иммунной системы. Результаты исследования ученых из Университета Южной Калифорнии опубликован
2012-05-03 15:28:00

Правительство РФ выделит 5 млрд рублей регионам с лучшими темпами снижения смертности и развитой системой семейной медицины
2012-05-01 23:34:00

Получены первые научные доказательства влияния наночастиц на устойчивость бактерий. Рост устойчивости в 200 раз
2012-05-01 23:31:00

Аспирин воздействует на опухолевые клетки, а также активирует распад жиров. К таким выводам пришли британские ученые из Университета Данди
2012-05-01 23:27:00

Установить минимальную цену пачки сигарет в размере 100 долларов США намерены власти Новой Зеландии уже к 2020 году
2012-04-30 22:59:00

Регулярное употребление ягод земляники и черники способствует сохранению высокой мозговой деятельности. Диета, эффективная в предупреждении слабоумия